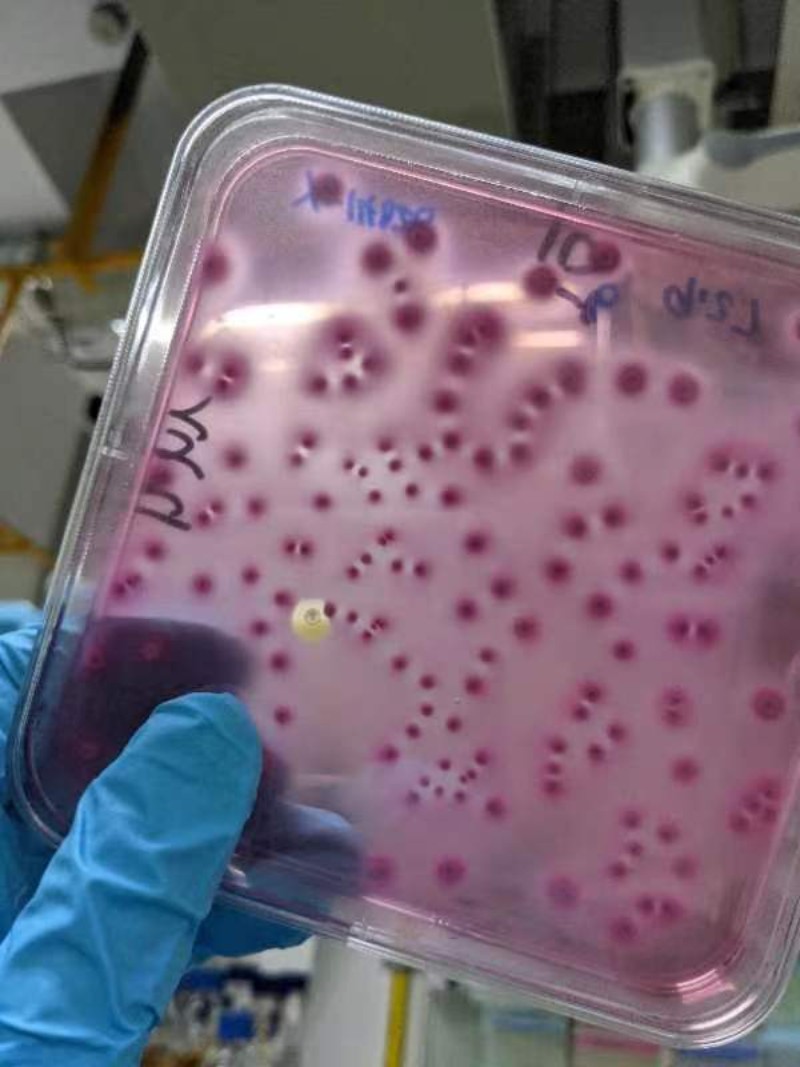
6380118365518513904216849

Ðû²¼ÈÕÆÚ£º£º10/5/2022
ÔÚÐÐÒµÄÚÄ¥Á·×¨ÒµÊÖÒÕ
ÔÚ¿ÎÌâ×éѧϰ¿ÆÑÐ֪ʶ
ÔÚ×ÔÔ¸»î¶¯ÖÐת´ï°®ÐÄ
Õâ¸öÊîÆÚ
ÄϹ¬NG28¼¯ÍÅÈËÓÃ×Ô¼ºµÄ·½Ê½
Ú¹ÊÍÊôÓÚÀí¹¤È˵ľ«²Ê
»ùÒòÊÖÒÕ¹«Ë¾
@2020¼¶Ö£ÑãÍ©
Õâ¸ö¼ÙÆÚÎÒÓÐÐÒÔÚ»ùÒòÊÖÒÕ¹«Ë¾¾ÙÐÐΪÆÚÒ»¸öÔµÄÊîÆÚʵϰ£¬£¬ÎÒʵϰµÄ¸ÚλÊDzúÆ·Ñз¢ºÍ΢ÉúÎïÄ¥Á·¡£ÎÒµÄÖ÷ҪʹÃüÊǺÍʦ½ãÒ»Æð̽Ë÷ʵÑéÌõ¼þ£¬£¬Ñз¢³ö×îÌù½ü¿Í»§ÐèÇóµÄ²úÆ·£¬£¬²¢¶Ô²úÆ·¾ÙÐÐÏà¹ØµÄ΢ÉúÎï¼ì²â¡£

ͨ¹ýÕâÒ»¸öÔµÄʵϰ£¬£¬ÎÒÊÕ»ñÁËÐí¶à¡£Ò»·½ÃæÎÒѧ»á½«Ñ§Ð£Ñ§Ï°µ½µÄÀíÂÛ֪ʶӦÓõ½ÊÂÇéÖУ¬£¬ÁíÒ»·½ÃæÎÒ¸ÐÊÜ×Ô¼ºÊµÑéʵ²ÙÄÜÁ¦»ñµÃÁ˺ܴóÌáÉý¡£ÔÚѧУÓÉÓÚʱ¼äÏÞÖÆ£¬£¬ÊµÑéÆ÷²Ä×¼±¸ÊÂÇé¶¼ÊÇÓɽÌÊÚ»òÕßѧ³¤Ñ§½ãÃÇ×ÊÖú×öºÃµÄ¡£¶øÕâ´Îʵϰ£¬£¬ÔòÐèÒª×Ô¼ºÌáǰԤ¹ÀºÃʵÑéËùÐèÆ÷²Ä²¢ÄÃÈ¥Ãð¾ú£¬£¬ÒÔÊǶÔʵÑé²Ù×÷Àú³ÌÒ²»áÔ½·¢ÊìϤ¡£³ý´ËÖ®Í⣬£¬ÎÒ·¢Ã÷ͨ¹ý²éÔÄÎÄÏ×¶ÔʵÑé·½°¸¾ÙÐÐÒ»Ö±¸ÄÉÆµÄÀú³ÌͦÓÐÒâ˼µÄ¡£ÔÚÒ»´Î´ÎÐÞ¸ÄʵÑé·½°¸²¢Ì½Ë÷³öÏëÒª»ñµÃµÄʵÑé״̬ºó»áÓÐÂúÂúµÄ³É¼¨¸Ð¡£

Õâ´ÎʵϰÎÒÒ²ºÜллÏÈÉúºÍͬʵÄÌåÌù×ÊÖú£¬£¬ÈÃÎҶȹýÁËÒ»¸ö³ä·ÖÇÒÊÕ»ñ¸»ºñµÄÒ»¸öÔÂ!
ҽѧĥÁ·Ëù
@2019¼¶×¿ìÏîÈ
½ñÄêÊî¼Ù£¬£¬ÎÒ˳Ëìͨ¹ýÁ˼òÀúɸѡ¼°ÃæÊÔ£¬£¬Ç°Íù¹ãÖÝÒ»¼ÒҽѧĥÁ·Ëù¾ÙÐÐʵϰ¡£Ä¥Á·Ëù×øÂäÓÚ¹ãÖݹÙÖÞÉúÎﵺ£¬£¬ÊÇÒ»¼ÒÒÔÖ×Áö»ùÒò²âÐò£¬£¬°©Ö¢Ôç¼ìΪÖ÷µÄҽѧĥÁ·¹«Ë¾¡£

ÓÉÓÚÎÒÊÇÉÐδ±¾¿Æ½áÒµµÄʵϰÉú£¬£¬ÒÔÊÇÔÝʱ²»ÔÊÐí½Ó´¥½¹µãʵÑ飬£¬Ö»ÄܾÙÐнÏÁ¿Ç°¶ËµÄÊÂÇé¡£Ò»×îÏÈÎÒÖ÷ÒªÈÏÕæÑùÆ·ÎüÊÕ£¬£¬ÔÚ½ÓÑùÊÒÎüÊÕÖÖÖÖDNA¡¢¡¢ÑªÒº¡¢¡¢ÐÂÏÊ×éÖ¯¡¢¡¢ÇÐÆ¬µÈÑù±¾£¬£¬²¢¾ÙÐÐÆðÔ´¼ì²â¡£º£ØÊºó£¬£¬ÎÒ±»°²Åŵ½Ñù±¾ÖÎÀíÊÒÊÂÇé¡£µ¥¶ÀÒ»ÈËÔÚÒ»¼äÓÐÊýʮ̨-80¡ãC³¬µÍαùÏäµÄʵÑéÊÒÀïÖü´æºÍ·ÏÆúÑùÆ·¡£ÎÒÐèҪƾ֤ҪÇóÒÔ¼°ÉúÑıê×¼£¬£¬½«PAXѪ½¬¡¢¡¢DNA¡¢¡¢RNA¡¢¡¢ºìϸ°ûºÍ°×ϸ°û·âĤ²¢Öü´æ£¬£¬ÒÔ¼°½«ÇÐÆ¬°´ÒªÇó·ÏÆú£¬£¬Í¬Ê±¾ÙÐйҺš£ÌìÌ컹ÐèÔÚ¸÷¸öʵÑéÊÒÖ®¼äÁ÷תDNA¡¢¡¢ÑªÒº¡¢¡¢À¯¿éµÈÑùÆ·¡£ÈÕ³£µÄÊÂÇéºÜÊÇæµ¡£

Ò»×îÏÈÎÒ²¢Ã»ÓÐ˳ӦÕâô¸ßÇ¿¶ÈÇÒÖØ¸´¶È¼«¸ßµÄÊÂÇ飬£¬ÔÚ½ÓÑùÊÒÓÐʱ¼äÒ»Õ¾¾ÍÊÇÒ»ÔçÉÏ£¬£¬¾³£·¸À§¡£º£ØÊºóÖð²½Ï°¹ßÁË£¬£¬±äµÃÔ½·¢ÓÐÄÍÐÄ£¬£¬¸üÄÜÔÚ¸ßÇ¿¶ÈµÄÊÂÇéϼá³Öרע¡£Ö®ºó±»°²Åŵ½µ¥¶ÀµÄʵÑéÊÒ£¬£¬Ò²Öð²½µÄ×îÏÈ˳Ӧ¹Â¿àÒÔ¼°·±ÖصÄÊÂÇé¡£Ïà±ÈÓÚרҵ·½Ã棬£¬ÕâÁ½¸öÔµÄʵϰ¶ÔÎÒ¸öÈËËØÑøÒÔ¼°¿¹Ñ¹ÄÜÁ¦ÌáÉý·½Ãæ×ÊÖú¸ü´ó£¬£¬Ò²ÈÃÎÒÓÖÒ»´ÎÌåÑéµ½ÁË¿ÆÑеļèÐÁ¡£

˵µãÌâÍâ»°£¬£¬Õâ¼Ò¹«Ë¾ÊÇNGS·½ÃæµÄÁìÍ·Ñò£¬£¬×÷ΪʵϰÉúÄÜÏíÊܵ½¹«Ë¾ÖÐÇï½ÚµÄ¸£Àû£¬£¬Æ½Ê±ÉÏϰàÒ²ÓÐר³µ½ÓË͵½µØÌú¿Ú£¬£¬Ã¿ÖÜÄÜÓÐÈýÌìµÄ¼Ù¡£ÉúÎﵺÉϼÈÓÐÎÞÈ˼ÝÊ»µÄС°Í£¬£¬Ò²ÓÐÎÞÈËÔç²ÍÊÛÂô³µ£¬£¬ÉÐÓÐ×Ô¶¯Ñ²ÂߵĻúеÈË£¬£¬Ðí¶à´óÐͿƼ¼ÐÍÆóÒµÒ²Âä»§ÓÚÉúÎﵺÉÏ¡£Õâ´ÎµÄʵϰÈÃÎÒÌå»áµ½³ýÁËÑо¿ÁìÓòºÍ¸ÚλƥÅä¶È£¬£¬ÕâЩ¹«Ë¾¹æÄ£¡£¡£¡¢¡¢¸£Àû¡¢¡¢ÇéÐεȡ°ÈíʵÁ¦¡±ÉϵÄÓŵãҲͬÑùÖ÷Òª¡£
ʳÎïÑз¢¹«Ë¾
@2019¼¶ÀîÞÈóò
Õâ¸öÊîÆÚ£¬£¬»³´§×ŶÔδ֪µÄìþìýµ£ÐÄ£¬£¬ÎÒǰÍùÍâµØÒ»¼ÒʳÎïÑз¢¹«Ë¾¾ÙÐÐʵϰ¡£¹«Ë¾¹æÄ£²»Ëã´ó£¬£¬¸÷¸ö²¿·Ö¶¼ÊÇϸÃÜÅþÁ¬ÔÚÒ»ÆðµÄ¡£ÊÖÒÕÖÐÐÄÓÉʵÑéÊÒ¡¢¡¢Æ·¹Ü²¿¡¢¡¢Ñз¢²¿×é³É£¬£¬ÓÉ´ËÀ´°ü¹ÜÇå¾²Éú²ú¡£

´øÎÒµÄʦ½ãÊÂÇéÄÜÁ¦ºÜÊǾ«²Ê£¬£¬Èκη±Ëöϸ½Ú¶¼Äܹ»Ë¼Á¿µ½¡£´ÓÔçÉÏÉèÖÃÈÜÒº×îÏÈ£¬£¬µ½³µ¼äÀýÐвÉÑù£¬£¬È¡ÌìÌìÐèÒª¼ì²âµÄʳÎï²¢¾ÙÐзÖÑù£¬£¬È»ºóϴƽ°å£¬£¬Ð´¼Í¼£¬£¬×îºó½øÈë΢¼ìÊÒÍ¿²¼Æ½°å£¬£¬Õâô¶à·½·¨Ëý¶¼¿ÉÒÔÓÐÌõ²»ÎɵÄÍê³É¡£µ±ÎÒÓöµ½²»ÇåÎúµÄµØ·½£¬£¬ËýÔÚ°Ùæ֮ÖÐÕվɻáºÜ×ÐϸµÄ½ÌÎÒ£¬£¬ÊµÑéÊÒÖ÷¹ÜºÍÆäËûͬÊÂÒ²¾³£ÔÚÊÂÇéÉϸøÓèÎÒ×ÊÖú¡£ÔÚ¸÷È˵Ä×ÊÖúÏ£¬£¬ÎҺܿìÕÆÎÕÁËÊÂÇéÁ÷³Ì£¬£¬Ë³Ó¦ÁËÊÂÇéÇéÐΣ¬£¬¸ßÖÊÁ¿µØÍê³ÉÊÂÇéʹÃü£¬£¬Ò²»ñµÃÁËÏòµ¼ºÍͬʵÄÈϿɡ£

Õâ´ÎµÄʵϰÈÃÎÒ˳ËìÄõ½ÁËÈËÉúÖ®ÖеÚһͰ½ð£¬£¬ÌåÑéµ½ÁËѧϰ֮ÍâÍêÈ«²î±ðµÄÉúÑÄ£¬£¬Ñ§»áÁËÔõÑùºÍÉç»áÉϵÄÈËÃÇ´ò½»µÀ£¬£¬Ã÷È·ÁËÔÚÍâÔõÑù×Ô¶¯È¥Ñ§Ï°£¬£¬Í¬Ê±Ò²¸ÐÊܵ½×¬Ç®µÄ²»Òס£Æ½Ê±ÎÒÃÇ×ÜÊÇËß¿à˵ÔÚѧУѧµ½µÄ֪ʶÔËÓò»µ½Êµ¼ùÖ®ÖУ¬£¬¿ÉÊÇÔÚÕâ¶ÎʵϰÀ£¬ÔõÑù½«ÑùÆ·½ÓÖÖµ½Æ½°åÉÏ£¬£¬ÔõÑùÍ¿²¼Æ½°å£¬£¬Êýƽ°å£¬£¬ÓÃʲôÑùµÄ×÷Óý»ù×÷ÓýʲôÀàÐ͵Äϸ¾ú»òÕßÖ²¡¾ú£¬£¬¶¼ÊÇÎÒÃÇÒ»¾ÔÚѧУѧϰ²¢Êµ¼ù¹ýµÄ¡£ÓеÄʱ¼ä´ÓѧУѧµ½µÄ֪ʶ¿ÉÄܲ¢²»¿ÉÍêÈ«ÕÕ°áµ½ÉúÑÄÊÂÇéÖ®ÖУ¬£¬¿ÉÊÇ´ÓÖÐѧµ½µÄÒªÁìÊÇͨÓõ쬣¬²¢ÇÒÄÜÈÃÎÒÃÇÒ»Ö±ÊÜÒæ¡£

ÎÒ²»Êdz±ÉÇÈË£¬£¬Ò²Ìý²»¶®³±ÉÇ»°¡£Ô±¾ÎÒÒÔΪ²»¿ÉÈÚÈëÕâ¸öȦ×Ó£¬£¬¿ÉÊÇÒ»ÆðÊÂÇ飬£¬Ò»Æð×¼±¸ÖÐÇïÍí»á£¬£¬Ò»Æð¾ÙÐÐÍŽ¨£¬£¬ÕâЩÈÕÈÕÒ¹Ò¹µÄÏà´¦¾¹ÈÃÎÒÓëËûÃÇÈÚΪһÌå¡£¸ÕÀ´¹«Ë¾Ê±ÎÒÒÔΪһ¸öÔÂÌ«ÄÑ¿°£¬£¬ÈÕ×Ó¹ýµÃÂý£¬£¬ÏÖÔÚÎÒ¾¹È»ÒÔΪʱ¼ä¹ýµÃÌ«¿ìÁË¡£ÎÒ×îÏḚ̀ÁµÕâ¸öµØ·½£¬£¬Ì°ÁµÎÒµÄͬÊÂÃÇ¡£ÎÒÏëÎҿ϶¨»á¼Ç×ÅÄãÃǵİɡ£

ʳÎïÑз¢¹«Ë¾
@2020¼¶Å·ÓÀÛÚ
Õâ¸öÊî¼ÙÎÒÔÚÒ»¼ÒʳÎïÑз¢¹«Ë¾¾ÙÐÐÁËΪÆÚÒ»¸öÔµÄʵϰ£¬£¬ÕâÊÇÒ»¼ÒÉæ¼°Ö²ÎïÌáÈ¡Îï¼°Æä×ÛºÏʹÓÃÆ·Ñз¢µÄÆóÒµ¡£×÷ΪһÃû»¯Ñ§¹¤³ÌרҵµÄѧÉú£¬£¬ÎÒʵϰµÄÖ÷ÒªÊÂÇéÊǶԹ«Ë¾Éú²ú³öÀ´µÄÖݪֲúÆ·¼°·´Ó³ÖÐÐÄÌå¾ÙÐÐÄ¥Á·ÆÊÎö¡£ÔÚÕâ´ÎʵϰÖУ¬£¬ÎÒ½«Æ½Ê±ÔÚ¿ÎÌÃÖÐѧϰµ½µÄÀíÂÛÔËÓõ½Êµ¼ùÖÐÈ¥£¬£¬Ô½·¢ÇåÎúµØÏàʶÁËÊé¼®ÉÏ֪ʶµÄÔÚ¹¤ÒµÉú²úÖеÄÏêϸӦÓá£


ÎÒ»¹Ê¹ÓÃÖÜÄ©ÐÝÏ¢µÄʱ¼ä£¬£¬¼ÌÐøÄ¥Á¶×Ô¼ºµÄÉãÓ°ÊÖÒÕ£¬£¬×öµ½ÊÂÇéÐËȤÁ½²»Îó¡£


ÄϹ¬NG28¼¯ÍÅ¿ÆÑпÎÌâ×é
@2020¼¶ÀîêÍãü
Õâ¸öÊîÆÚ£¬£¬ÎÒÔÚÁº¼ÎÑÔÏÈÉúµÄÏîÄ¿×éÉÏѧϰ£¬£¬ÔÚËûµÄ²©Ê¿ÉúÖ¸µ¼Ï¿ªÕ¹ÊµÑé¡£Êî¼ÙµÄµÚÒ»½×¶ÎµÄÊǾÙÐоúµÄÄÍÒ©²âÊÔ£¬£¬ÒÔÊÇÌìÌì¶¼¿ÉÒÔ¿´µ½ÕâÑùµÄ¡°Ã×ÀÏÊ󡱡£


ÏÖÔÚ¾ÙÐеÄÊÇÊß²Ëݪֲ£¬£¬ÒÔ¼°Ò»Ð©¾úµÄ½ÓºÏʵÑé¡£

ËäÈ»´ó²¿·Öʱ¼ä¶¼¡°×¡¡±ÔÚʵÑéÊÒ£¬£¬µ«ÄÜѧϰµ½ÐµĹ¤¾ßÒÔ¼°×ö¿ÆÑеÄ̬¶È£¬£¬Ò²±ãÊ®·ÖÖª×㿪ÐÄ¡£º£ºÜллÁº¼ÎÑÔÏÈÉú£¬£¬ÈÃÎÒÄܹ»½Ó´¥µ½×Ô¼ºÏ²»¶µÄ¹¤¾ß£¬£¬ºÃ±ÈÉúÎïÐÅϢѧ¡£ÔÚÏîÄ¿×éµÄʵÑéÖ®Ó࣬£¬ÎÒ»¹×ÔѧÁËÉúÎïÐÅϢѧÏà¹ØµÄÈí¼þ£¬£¬ÐÖú·ÒëÍê³ÉÎÒÃÇÏîÄ¿µÄÌá°¸£¬£¬ÕÆÎÕÁËÔõôÓÃBioRender£¨Ò»ÖÖ¿ÆÑÐÖÆÍ¼¹¤¾ß£©»æÍ¼¡£

×ܶøÑÔÖ®ÔÚÏîÄ¿×éµÄÿһÌì¶¼¹ýµÃÊ®·Ö³ä·Ö¡£
ÈýÏÂÏç×ÔÔ¸»î¶¯
Õâ¸ö¼ÙÆÚ£¬£¬ÉÐÓÐÕâÑùÒ»ÅúÈË£¬£¬ËûÃÇÔÚÄϹ¬NG28¼¯ÍÅÍÅίÏòµ¼Ï¼ÓÈëÁúºþÇøºôԮͨÉ繤·þÎñÖÐÐÄ¿ªÕ¹µÄ¹«Òæ×ÔÔ¸»î¶¯£¬£¬ÎªÏ½Çø»§¼®¸¸ÀÏÌṩÁ¿ÑªÑ¹¡¢¡¢Èö²¥·ÀÕ©ÆÖªÊ¶µÈһЩÁ¦ËùÄܼ°µÄÐÖú£¬£¬ËÍÉÏ´óѧÉú¶ÔÍíÄêÈ˵ÄÒ»·Ý¾ì×¢£¬£¬Èö²¥×ÔÔ¸Õß¾«Éñ¡£


¶¬¼¾Ñ§ÆÚ½«ÖÁ£¬£¬Ï£Íû¸÷ÈËÄÜ´ø×Å¼ÙÆÚÂúÂúµÄÊÕ»ñ£¬£¬¿ªÆôÐÂÒ»ÂÖµÄÄϹ¬NG28¼¯ÍÅÉúÑÄ£¡£¡£¡
© ÄϹ¬NG28¼¯ÍÅ °æÈ¨ËùÓÐ | ÔÁICP±¸17036470ºÅ